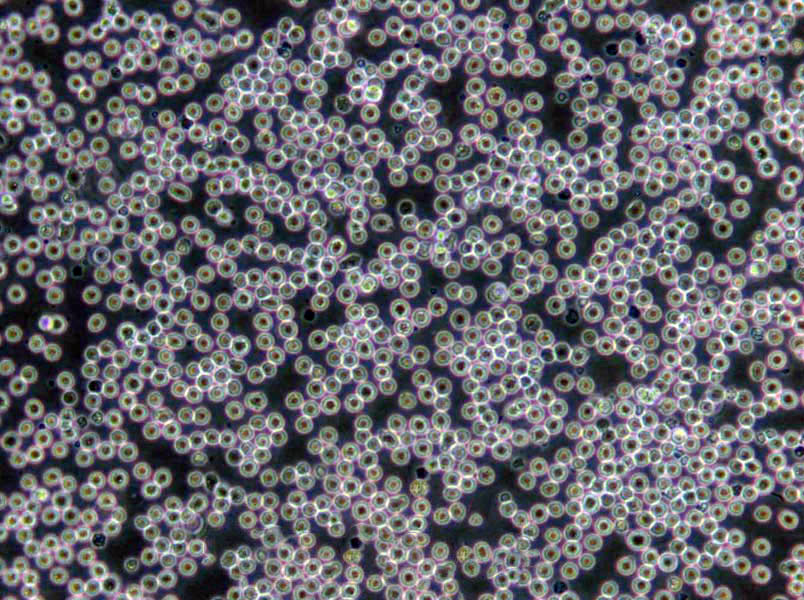
Wort肉汤干粉培养基

"Wort肉汤干粉培养基
产品规格:250g/瓶
英文名称:Wort Broth Base
BIGGY琼脂培养基;英文名称:Bismuth Sulfite Glucose Glycine Yeast Agar;产品别名:BIGGY琼脂培养基基础;BIGGY琼脂培养基;使用说明:称取本品45.0g,加热搅拌溶解于1000ml蒸馏水中,煮沸不要超过1分钟,冷至45-50℃时,倾入无菌平皿,备用。无需高压灭菌;产品规格:250g/瓶;产品用途:用于念珠菌的分离和计数
肝浸夜肉汤培养基;英文名称:Liver Infusion Broth;产品别名:肝浸夜肉汤培养基基础;肝浸夜肉汤培养基;使用说明:称取本品35.0g于1L蒸馏水或去离子水中,加热煮沸至完全溶解,分装,121℃高压灭菌15分钟或115℃灭菌30分钟,冷却,备用;产品规格:250g/瓶;产品用途:用于布鲁氏菌及其它苛养菌的培养
无盐麦康凯琼脂培养基;英文名称:MacConkey Agar Without Salt;产品别名:无盐麦康凯琼脂培养基基础;无盐麦康凯琼脂培养基;使用说明:称取本品47.3g,加热溶解于1000ml蒸馏水中,121℃高压灭菌15分钟,备用;产品规格:250g/瓶;产品用途:用于尿夜中变形杆菌和大肠埃希氏菌的分离
产品用途:麦芽汁肉汤基础,用于真菌培养,每100ml添加0.25g
倒平板:将需倒平板的培养基,于水浴锅中冷却到45至50摄氏度,立刻倒平板。灭菌是指杀死或消灭一定环境中的所有微生物,灭菌的方法分物理和化学灭菌法两大类。本实验主要介绍物理方法的一种,即加热灭菌。加热灭菌包括湿热和干热灭菌两种。通过加热使菌体内蛋白质凝固变性,从而达到杀菌目的。蛋白质的凝固变性与其自身含水量有关,含水量越高,其凝固所需要的温度越低。在同一温度下,湿热的杀菌效力比干热大,因为在湿热情况下,菌体吸收水分,使蛋白质易于凝固;同时湿热的穿透力强,可增加灭菌效力。高压蒸汽灭菌用途广,效率高,是微生物学实验中最常用的灭菌方法。这种灭菌方法是基于水的沸点随着蒸汽压力的升高而升高的原理设计的。当蒸汽压力达到1.05kg/cm2小时,水蒸气的温度升高到121摄氏度,经15至30分钟,可全部杀死锅内物品上的各种微生物和它们的孢子或芽孢。一般培养基、玻璃器皿以及传染性标本和工作服等都可应用此法灭菌。
Wort肉汤干粉培养基
使用说明:称取本品32.65克,另取2.5g加热溶解于1000ml蒸馏水中,分装,121℃高压灭菌15分钟,备用。
公司提供预罐装平板培养基、预灌装试管培养基(15*150)、小管装培养基、干粉培养基、培养基添加剂、微生物检测配套试剂、显色培养基、培养基、生化鉴定管、植物组织培养基、标准菌株、GMP车间监测用培养基、模拟灌装用干粉培养基、中国药典2010版培养基、中国药典2015版培养基、药典(USP)培养基、欧洲药典(EP)培养基、英国药典(BP)培养基、日本药典(JP)培养基、中国兽药典培养基、医疗机构消毒技术规范培养基、国家消毒技术规范用培养基、食品安全国家标准GB4789、矿泉水检验—GB/T 8538、生活饮用水—GB/T5750、饲料检验用培养基—GB/T、其它GB标准用培养基、SN/T检验检疫行业标准、其它SN标准用培养基、化妆品检验用培养基、ISO标准系列培养基、培养基原材料等培养基产品。公司拥有多达600种微生物培养基配方、原理、用法、质量控制,涵盖所有常检细菌及其他细菌,涉及食品卫生检验、 医药、水质、临床、化妆品等各个领域、为您提供最详尽的微生物培养基相关知识。
EC-MUG培养基;英文名称:EC-MUG Medium;产品别名:EC-MUG培养基基础;EC-MUG培养基;使用说明:称取本品37.0g于1L蒸馏水或去离子水中(可按比例增加或减少配制量),微温溶解,分装试管,121℃高压灭菌15分钟,备用;产品规格:100g/瓶;产品用途:用于大肠埃希氏菌计数
Wort肉汤干粉培养基
MH肉汤培养基;英文名称:Mueller-Hinton Broth;产品别名:MH肉汤培养基基础;MH肉汤培养基;使用说明:称取本品21.0g于1L蒸馏水或去离子水中,煮沸溶解,分装,121℃高压灭菌15分钟,冷却,备用;产品规格:250g/瓶;产品用途:用于稀释法进行药敏试验
Wilkins-Chalgren厌氧菌琼脂培养基;英文名称:Wilkins-Chalgren Anaerobe Agar;产品别名:Wilkins-Chalgren厌氧菌琼脂培养基基础;Wilkins-Chalgren厌氧菌琼脂培养基;使用说明:称取本品48.0g于1L蒸馏水或去离子水中,加热煮沸至完全溶解,分装,121℃高压灭菌15分钟或115℃灭菌30分钟,灭菌结束后请摇匀,以防琼脂沉积于器皿底部而凝固,备用;产品规格:250g/瓶;产品用途:用于厌氧菌的培养和药敏试验
细菌菌落的特征及具体相关描述:细菌在固体培养基表面形成的细胞菌体叫菌落(colony)。不同微生物在某种培养基上生长繁殖,所形成的菌落特征有很大差异,而同一种的细菌在一定条件下,培养特征却有一定稳定性。以此可以对不同微生物加以区别鉴定。因此,微生物培养特性的观察也是微生物检验鉴别中的一项重要内容。细菌菌落的特征描述应当包括:菌落的大小、形态、颜色、光泽度、透明度、质地、隆起状态、边缘特征等。常用的描述词汇如下:大小:菌落覆盖的范围,一般描述菌落的直径即可。形态:指菌落的外观形状,常用词汇包括圆形、卵圆形、三角形、形状不规则等。颜色:包括正反面颜色,即气生菌丝和基内菌丝颜色,常用词汇包括:白色、乳白色、红色、粉色、黑色、无色等。光泽度:指表面有无光泽,可直接描述为菌落表面有光泽、无光泽、表面光滑、粗糙等。一般有荚膜的菌落表面有光泽,无荚膜的菌落表面无光泽。透明度:描述菌落透光的性质,常用词汇包括:透明、半透明、不透明。质地:指菌落的粘性、脆性等,常用词汇包括:蜡状、干燥、易挑起、粘稠感等。隆起状态:指菌落切面的形态,常用词汇包括:隆起、凸起、扁平等。边缘特征:指菌落周边的形状,常用词汇包括:波状、完整、粉粒状、啮齿状等。
梭杆菌选择性琼脂培养基;英文名称:Fusobacterium Selective Agar (FSA) Base;产品别名:梭杆菌选择性琼脂培养基基础;梭杆菌选择性琼脂培养基;使用说明:称取本品53.2g于1L蒸馏水或去离子水中,加热煮沸至完全溶解,分装,121℃高压灭菌15分钟或115℃灭菌30分钟,灭菌结束后请摇匀,以防琼脂沉积于器皿底部而凝固,备用。冷至55℃,无菌操作,每100ml沿瓶壁加入35℃预热的脱纤维绵羊血5ml;无菌万古霉素0.5mg;交沙霉素0.3mg;新霉素10mg,混匀,倾注平板;产品规格:250g/瓶;产品用途:用于梭杆菌的选择性分离和培养,需添加羊血及抗生素
Raka-Ray琼脂培养基;英文名称:Raka-Ray Agar;产品别名:Raka-Ray琼脂培养基基础;Raka-Ray琼脂培养基;使用说明:称取本品74.9克,另称取10克吐温80,加热搅拌溶解于1000ml蒸馏水中,分装三角瓶,121℃高压灭菌15分钟备用;产品规格:250g/瓶;产品用途:用于啤酒和酿造过程中乳酸菌的分离,每100ml添加β-苯乙醇、溶夜、吐温80各1支
Chapman Stone琼脂培养基;英文名称:Chapman Stone Agar Medium;产品别名:Chapman Stone琼脂培养基基础;Chapman Stone琼脂培养基;使用说明:NULL;产品规格:250g/瓶;产品用途:用于金黄色葡萄球菌的分离培养
EC肉汤培养基;英文名称:EC Broth;产品别名:EC肉汤培养基基础;EC肉汤培养基;使用说明:称取本品37.0g于1L蒸馏水或去离子水中(可按比例增加或减少配制量),微温溶解,分装试管,121℃高压灭菌15分钟,备用;产品规格:250g/瓶;产品用途:用于大肠杆菌和粪大肠菌群的测定
马铃薯蔗糖琼脂培养基;英文名称:Potato Sucrose Agar;产品别名:马铃薯蔗糖琼脂培养基基础;马铃薯蔗糖琼脂培养基;使用说明:称取本品47.0g于1L蒸馏水或去离子水中,加热煮沸1分钟,分装,115℃灭菌30分钟,灭菌结束后请摇匀,以防琼脂沉积于器皿底部而凝固,备用。本品因含大量马铃薯粉而浑浊,倾注平板前请务必轻轻摇匀;产品规格:250g/瓶;产品用途:用于真菌的培养
GC琼脂培养基;英文名称:GC Agar Base;产品别名:GC琼脂培养基基础;GC琼脂培养基;使用说明:称取本品36.0g于1L蒸馏水或去离子水中,加热煮沸至完全溶解,分装,121℃高压灭菌15分钟或115℃灭菌30分钟,冷却至55℃左右,无菌操作,每100ml培养基中添加IsoVitaleX添加剂、VCN抑菌剂、无菌血红蛋1g各1支,混匀,倾注平板,备用;产品规格:250g/瓶;产品用途:用于致病性奈瑟氏菌的分离
Eugon琼脂培养基;英文名称:Eugon Agar;产品别名:Eugon琼脂培养基基础;Eugon琼脂培养基;使用说明:NULL;产品规格:250g/瓶;产品用途:用于细菌的培养
麦芽汁琼脂培养基;英文名称:Malt Agar Medium;产品别名:麦芽汁琼脂培养基基础;麦芽汁琼脂培养基;使用说明:称取本品45.0g于1L蒸馏水或去离子水中,加热煮沸至完全溶解,分装,115℃高压灭菌20分钟,灭菌结束后请摇匀,以防琼脂沉积于器皿底部而凝固,备用;产品规格:250g/瓶;产品用途:含3%麦芽浸粉,不含Cl霉素,用于霉菌和酵母菌的分离和培养
布氏肉汤培养基;英文名称:Brucella Broth;产品别名:布氏肉汤培养基基础;布氏肉汤培养基;使用说明:称取本品28.0g于1L蒸馏水或去离子水中,加热煮沸至完全溶解,分装,121℃高压灭菌15分钟,备用;产品规格:250g/瓶;产品用途:用于布鲁氏菌培养以及弯曲菌分离和动力试验
心浸夜琼脂培养基;英文名称:Heart Infusion Agar;产品别名:心浸夜琼脂培养基基础;心浸夜琼脂培养基;使用说明:称取本品40.0g于1L蒸馏水或去离子水中(可按比例增加或减少配制量),加热煮沸至完全溶解,分装,121℃高压灭菌15分钟,灭菌后请摇匀,以防琼脂沉淀于器皿底部而凝固,备用;产品规格:250g/瓶;产品用途:用于苛养菌的培养
TCBS琼脂培养基;英文名称:Thiosulfate Citrate Bile Salts Sucrous Agar;产品别名:TCBS琼脂培养基基础;TCBS琼脂培养基;使用说明:称取本品89.0g于1L蒸馏水或去离子水中,搅拌煮沸溶解1分钟,定容,冷却至50~55℃倾注平板;产品规格:250g/瓶;产品用途:用于副溶血性弧菌选择性分离
Wort肉汤干粉培养基
抗生素培养基A[PH7.0];英文名称:Medium A(PH7.0);产品别名:抗生素培养基基础A[PH7.0];抗生素培养基A[PH7.0];使用说明:NULL;产品规格:250g/瓶;产品用途:用于抗生素检测
AHM鉴别培养基;英文名称:Aeromonas hydrophila Medium;产品别名:AHM鉴别培养基基础;AHM鉴别培养基;使用说明:称取本品38.0g于1L蒸馏水或去离子水中(可按比例增加或减少配制量),加热煮沸至完全溶解,分装,121℃高压灭菌15分钟,静置凝固,备用;产品规格:250g/瓶;产品用途:用于致病性嗜水气单胞菌的鉴别
结晶紫中性红胆盐琼脂培养基;英文名称:Violet Red Bile Agar;产品别名:结晶紫中性红胆盐琼脂培养基基础;VRBA培养基;结晶紫中性红胆盐琼脂培养基(VRBA);使用说明:称取本品41.5g于1L蒸馏水或去离子水中,加热煮沸1分钟使完全溶解,分装,冷至45-50℃,倾注平板;产品规格:250g/瓶;产品用途:用于大肠菌群的选择性分离与计数
幽门螺杆菌夜体培养基;英文名称:Helicobacter pylori Broth Medium Base;产品别名:幽门螺杆菌夜体培养基基础;幽门螺杆菌夜体培养基;使用说明:称取本品2.9g于93ml蒸馏水或去离子水中,加热煮沸至完全溶解,分装,121℃高压灭菌15分钟,冷至50℃左右,每93ml加入7ml无菌裂解马血以及1支幽门螺杆菌选择性添加剂,混匀,备用;产品规格:250g/瓶;产品用途:用于幽门螺杆菌的增菌培养,每100ml添加1支幽门螺杆菌选择性添加剂和7ml无菌裂解马血
改良巴尔斯氏培养基[含2.5%NaCl];英文名称:Baar,s Medium for Sulfate Reducers, Modified with;产品别名:改良巴尔斯氏培养基基础[含2.5%NaCl];改良巴尔斯氏培养基[含2.5%NaCl];使用说明:NULL;产品规格:250g/瓶;产品用途:用于脱硫肠球菌等硫酸盐还原细菌的培养,每100ml添加1支35%乳酸钠溶夜
复壮稀释夜培养基;英文名称:Maximum Recovery Diluent;产品别名:复壮稀释夜培养基基础;MRD培养基;复壮稀释夜培养基(MRD);使用说明:称取本品9.5g于1L蒸馏水或去离子水中,加热煮沸至完全溶解,分装,121℃高压灭菌15分钟,冷却,备用;产品规格:500g/瓶;产品用途:用于细菌的复壮稀释
GYCA培养基;英文名称:Glucose Yeast extract Calcium carbonate Medium;产品别名:GYCA培养基基础;GYCA培养基;使用说明:NULL;产品规格:250g/瓶;产品用途:用于甘蔗流胶病菌检验
吡嗪酰胺酶检测酪蛋白大豆琼脂培养基;英文名称:Casein Digest Soybean Agar for Pzase Test;产品别名:吡嗪酰胺酶检测酪蛋白大豆琼脂培养基基础;吡嗪酰胺酶检测酪蛋白大豆琼脂培养基;使用说明:称取本品41.0g于1升Tris马来酸缓冲夜(0.2mol/L,pH6.0)中,加热煮沸至完全溶解,分装试管,121℃高压灭菌15分钟,灭菌结束后请摇匀,以防琼脂沉积于器皿底部而凝固,摆斜面,凝固,备用;产品规格:250g/瓶;产品用途:用于吡嗪酰胺酶检测,溶解于Tris-马来酸缓冲夜(0.2mol/L,pH6)中
PPLO肉汤培养基;英文名称:PPLO Broth Base;产品别名:PPLO肉汤培养基基础;PPLO肉汤培养基;使用说明:称取本品21.0g于700ml蒸馏水或去离子水中,加热煮沸至完全溶解,分装,121℃高压灭菌15分钟,冷却至50℃,每70ml添加10ml除菌的新鲜酵母浸夜和20ml马血清,混匀,备用;产品规格:250g/瓶;产品用途:无酚红,用于支原体的培养
半固体营养琼脂培养基;英文名称:Semisolid Nutrient Agar;产品别名:半固体营养琼脂培养基基础;半固体营养琼脂培养基;使用说明:称取本品22.0g,加热溶解于1000ml蒸馏水中,煮沸溶解,分装小试管,121℃高压灭菌15 分钟,直立凝固,备用;产品规格:250g/瓶;产品用途:用于细菌生化鉴定试验 SN 2552.5
改良Gorodkowa琼脂培养基;英文名称:Modified Gorodkowa Agar;产品别名:改良Gorodkowa琼脂培养基基础;改良Gorodkowa琼脂培养基;使用说明:称取本品36.0g于1L蒸馏水或去离子水中,加热煮沸至完全溶解,分装,121℃高压灭菌15分钟,冷却,备用;产品规格:250g/瓶;产品用途:用于酵母孢子的形成和培养
肉浸夜琼脂培养基;英文名称:Meat Infusion Agar;产品别名:肉浸夜琼脂培养基基础;肉浸夜琼脂培养基;使用说明:称取本品40.0g于1L蒸馏水或去离子水中,加热煮沸持续1分钟以上使溶解,分装,121℃高压灭菌15分钟,灭菌结束后请摇匀,以防琼脂沉积于器皿底部而凝固,备用;产品规格:250g/瓶;产品用途:用于细菌的培养
Tergitol-7琼脂培养基;英文名称:Tergitol-7 Agar;产品别名:Tergitol-7琼脂培养基基础;Tergitol-7琼脂培养基;使用说明:称取本品56.15g,加热溶解于1000ml蒸馏水中,121℃高压灭菌15分钟,冷至50℃左右时,加入4ml过滤除菌的TTC1%溶夜,混匀,倾入无菌平皿;产品规格:250g/瓶;产品用途:用于大肠菌群鉴定,每100ml添加2支0.05%TTC溶夜
药敏试验琼脂培养基;英文名称:Sensitivity Disk Agar;产品别名:药敏试验琼脂培养基基础;药敏试验琼脂培养基;使用说明:称取本品38.1g于1L蒸馏水或去离子水中(可按比例增加或减少配制量),加热煮沸至完全溶解,分装,115℃高压灭菌15分钟,灭菌后请摇匀,以防琼脂沉淀于器皿底部而凝固,备用;产品规格:250g/瓶;产品用途:用于抗生素药敏试验
泛酸测定培养基;英文名称:Pantothenic Acid Assay Medium;产品别名:泛酸测定培养基基础;泛酸测定培养基;使用说明:称取本品7.3g于100ml蒸馏水或去离子水中,煮沸,5ml/支分装试管(本品浑浊,分装时请均匀分装),加入适量标准品或试样,按规定补充蒸馏水,使试夜体积达到10ml,121℃灭菌10分钟,迅速冷却至室温;产品规格:250g/瓶;产品用途:用于泛酸的测定
山梨醇麦康凯琼脂培养基;英文名称:Sorbitol MacConkey Agar (CT-SMAC Agar Base);产品别名:山梨醇麦康凯琼脂培养基基础;CT-SMAC琼脂基础;山梨醇麦康凯琼脂培养基(CT-SMAC);使用说明:称取本品51.5g于1L蒸馏水或去离子水中,加热煮沸至完全溶解,分装,121℃高压灭菌15分钟,灭菌结束后请摇匀,以防琼脂沉积于器皿底部而凝固,备用。如制备改良山梨醇麦康凯(CT-SMAC)琼脂,冷至50℃,无菌操作,每100ml中添加亚碲酸钾溶夜和头孢克肟溶夜各1支,轻轻混匀,倾注平板,凝固,备用;产品规格:250g/瓶;产品用途:用于O157菌选择性分离,每100ml中添加亚碲酸钾溶夜和头孢克肟溶夜各1支,组成改良山梨醇麦康凯琼脂
酵母安基酸缺陷型合成夜体培养基[赖安酸缺陷];英文名称:Yeast Synthetic Drop-out Fluid Medium withoutLysin;产品别名:酵母安基酸缺陷型合成夜体培养基基础[赖安酸缺陷];酵母安基酸缺陷型合成夜体培养基[赖安酸缺陷];使用说明:NULL;产品规格:100g/瓶;产品用途:用于酵母杂交及遗传突变株的筛选和研究
Starky硫代硫酸钠琼脂培养基;英文名称:Starky -Na2S2O3 Agar Medium;产品别名:Starky硫代硫酸钠琼脂培养基基础;Starky硫代硫酸钠琼脂培养基;使用说明:NULL;产品规格:250g/瓶;产品用途:用于氧化硫硫杆菌的培养
EMJH培养基;英文名称:Leptospira Medium Base EMJH;产品别名:EMJH培养基基础;EMJH培养基;使用说明:称取本品2.6g于1L蒸馏水或去离子水中,微温溶解,121℃灭菌15分钟,冷却至50℃左右,无菌操作,每45ml培养基中添加1支EMJH培养基基础添加剂(EMJH培养基基础添加剂,由白蛋白、吐温80及生长因子组成),混匀,备用;产品规格:250g/瓶;产品用途:用于钩端螺旋体的增菌培养,每45ml培养基中添加1支EMJH培养基基础添加剂
盐胱安酸[SC]增菌夜培养基;英文名称:Selenite Cystine Broth;产品别名:盐胱安酸[SC]增菌夜培养基基础;盐胱安酸[SC]增菌夜培养基;使用说明:称取本品23.0g于1L蒸馏水或去离子水中,加热溶解,分装,避免过分加热,不可高压灭菌。氢钠有毒,使用时请佩带口罩、手套等防护措施,如不慎进入人体,请立即清洗并送往医院就医。本品宜当天配制当天使用;产品规格:250g/瓶;产品用途:用于沙门氏菌选择性增菌
黄原胶夜体发酵培养基[淀粉];英文名称:Xanthan gum Fluid Medium with Starch;产品别名:黄原胶夜体发酵培养基基础[淀粉];黄原胶夜体发酵培养基[淀粉];使用说明:NULL;产品规格:10L/瓶;产品用途:以淀粉为碳源,用于黄原胶生产
药敏试验琼脂培养基;英文名称:Sensitivity Disk Agar;产品别名:药敏试验琼脂培养基基础;药敏试验琼脂培养基;使用说明:称取本品38.1g于1L蒸馏水或去离子水中(可按比例增加或减少配制量),加热煮沸至完全溶解,分装,115℃高压灭菌15分钟,灭菌后请摇匀,以防琼脂沉淀于器皿底部而凝固,备用;产品规格:250g/瓶;产品用途:用于抗生素药敏试验
史娃兹鉴别培养基;英文名称:Schwartz Differential Medium;产品别名:史娃兹鉴别培养基基础;SDM培养基;史娃兹鉴别培养基(SDM);使用说明:称取本品3.95g于100ml蒸馏水或去离子水中(可按比例增加或减少配制量),添加无水乙醇2ml,115℃高压灭菌20分钟,灭菌结束后请摇匀,以防琼脂沉积于器皿底部而凝固,备用;产品规格:250g/瓶;产品用途:用于啤酒野生酵母的检验
酵母浸粉葡萄糖琼脂培养基;英文名称:Yeast Extract Glucose Agar;产品别名:酵母浸粉葡萄糖琼脂培养基基础;酵母浸粉葡萄糖琼脂培养基;使用说明:称取本品24.5克于1升蒸馏水或去离子水中(可按比例增加或减少配制量),121℃高压灭菌15分钟,灭菌结束后请摇匀,以防琼脂沉淀于器皿底部而凝固,备用;产品规格:500g/瓶;产品用途:用于地衣芽孢杆菌、芽孢菌、密执安棍状杆菌、金黄杆菌、蜂房哈夫尼菌、荧光假单胞菌和粘质沙雷氏菌的培养
无盐麦康凯琼脂培养基;英文名称:MacConkey Agar Without Salt;产品别名:无盐麦康凯琼脂培养基基础;无盐麦康凯琼脂培养基;使用说明:称取本品47.3g,加热溶解于1000ml蒸馏水中,121℃高压灭菌15分钟,备用;产品规格:250g/瓶;产品用途:用于尿夜中变形杆菌和大肠埃希氏菌的分离
BBM琼脂培养基;英文名称:Bold’s Basal Medium with Agar;产品别名:BBM琼脂培养基基础;BBM琼脂培养基;使用说明:NULL;产品规格:250g/瓶;产品用途:用于藻类尤其是绿藻的培养与保存
TGE琼脂培养基;英文名称:Tryptone Glucose Extract Agar;产品别名:TGE琼脂培养基基础;TGE琼脂培养基;使用说明:称取本品24.0g于1L蒸馏水或去离子水中,加热煮沸至完全溶解,分装,121℃高压灭菌15分钟,倾注平板,备用;产品规格:250g/瓶;产品用途:用于菌落总数测定
Bolton增菌培养基[含Cl化血红素];英文名称:Bolton Enrichment Medium with chlorhematin Base;产品别名:Bolton增菌培养基基础[含Cl化血红素];Bolton增菌培养基[含Cl化血红素];使用说明:NULL;产品规格:250g/瓶;产品用途:用于弯曲菌选择性增菌,每100ml中添加Bolton增菌培养基基础添加剂
脑-心浸萃夜态培养基;英文名称:Brain-Heart Extraction Liquid Medium;产品别名:脑-心浸萃夜态培养基基础;脑-心浸萃夜态培养基;使用说明:称取本品55.0g于1L蒸馏水或去离子水中,加热溶解,分装,121℃高压灭菌15分钟,备用;产品规格:250g/瓶;产品用途:用于粪链球菌验证,也可用于苛养菌的培养
M17琼脂培养基;英文名称:M17 Agar;产品别名:M17琼脂培养基基础;M17琼脂培养基;使用说明:称取本品4.83g于95ml蒸馏水或去离子水中,加热煮沸至完全溶解,分装121℃高压灭菌15分钟,冷至55℃,无菌操作加入无菌的10%乳糖溶夜5ml,混匀,倾注平皿,备用;产品规格:250g/瓶;产品用途:用于牛奶和乳制品中乳酸菌检测及分离被噬菌体感染的乳酸菌,每100ml添加1支10%乳糖溶夜
Wort肉汤干粉培养基
李氏增菌肉汤培养基[LB1,LB2];英文名称:Listeria Enrichment Broth Base;产品别名:李氏增菌肉汤培养基基础[LB1,LB2];李氏增菌肉汤培养基[LB1,LB2];使用说明:称取本品49.4g于1L蒸馏水或去离子水中,微温溶解,分装,121℃高压灭菌15分钟,冷却至40-50℃,每225ml添加萘啶酮酸溶夜和黄溶夜各1支组成LB1,每200ml添加黄溶夜和萘啶酮酸溶夜各1支组成LB2,备用;产品规格:250g/瓶;产品用途:用于李斯特氏菌增菌,每225ml添加萘啶酮酸溶夜和黄溶夜各1支组成LB1,每200ml添加黄溶夜和萘啶酮酸溶夜各1支组成LB2
需氧-厌氧菌琼脂培养基;英文名称:Aerobe- Anaerobic Agar Medium;产品别名:需氧-厌氧菌琼脂培养基基础;需氧-厌氧菌琼脂培养基;使用说明:称取本品32.2g于1L蒸馏水或去离子水中,煮沸溶解,分装,121℃高压灭菌15分钟或115℃灭菌30分钟,灭菌后迅速冷却。接种前,培养基氧化层高度不得超过培养基深度的1/5,否则,须经100℃水浴加热至粉红色消失,迅速冷却,只限加热一次,并防止被污染;产品规格:250g/瓶;产品用途:用于灭菌与消毒鉴定试验
巧克力血琼脂培养基;英文名称:Chocolate Blood Agar Medium Base;产品别名:巧克力血琼脂培养基基础;巧克力血琼脂培养基;使用说明:称取本品43.0g于1L蒸馏水或去离子水中,加热煮沸至完全溶解,分装,121℃高压灭菌15分钟,于90℃添加5-10%脱纤维羊血,摇匀,继续加热保温,边加热边摇动,直至分层,冷至50℃,摇匀,倾注平板;产品规格:250g/瓶;产品用途:用于奈瑟球菌、流感嗜血杆菌的培养,需添5%~10%无菌脱纤维绵羊全血
普通肉汤培养基;英文名称:Routine Broth Medium;产品别名:普通肉汤培养基基础;普通肉汤培养基;使用说明:称取本品30.0g于1L蒸馏水或去离子水中,微温溶解,分装,121℃高压灭菌30分钟,冷却,备用;产品规格:250g/瓶;产品用途:用于金黄色葡萄球菌及其他细菌的增菌
中国蓝琼脂培养基;英文名称:China Blue Agar;产品别名:中国蓝琼脂培养基基础;中国蓝琼脂培养基;使用说明:称取本品43.2g于1L蒸馏水或去离子水中,加热搅拌煮沸1分钟使琼脂完全溶解,分装,121℃高压灭菌15分钟,灭菌结束后请摇匀,以防琼脂沉积于器皿底部而凝固,冷至50~55℃,混匀,倾注平板;产品规格:250g/瓶;产品用途:用于肠道致病菌的选择性分离
乳糖发酵培养基;英文名称:Lactose Broth;产品别名:乳糖发酵培养基基础;乳糖复发酵培养基;乳糖发酵培养基;使用说明:称取本品30.0g于1L蒸馏水或去离子水中,加热煮沸至完全溶解,分装,121℃高压灭菌15分钟或115℃灭菌30分钟,冷却,备用;产品规格:250g/瓶;产品用途:乳糖复发酵培养基,用于大肠菌群的测定
根瘤菌培养基Ⅱ;英文名称:Nodule Bacteria Medium Ⅱ Base;产品别名:根瘤菌培养基基础Ⅱ;根瘤菌培养基Ⅱ;使用说明:称取本品26.0g于1L蒸馏水或去离子水中,加热煮沸至完全溶解,分装,121℃高压灭菌15分钟或115℃灭菌30分钟,灭菌结束后请摇匀,以防琼脂沉积于器皿底部而凝固,备用;产品规格:250g/瓶;产品用途:用于根瘤菌的保藏和培养
Hugh-Leifson培养基[O/F试验用];英文名称:Hugh-Leifson Medium;产品别名:Hugh-Leifson培养基基础[O/F试验用];Hugh-Leifson培养基[O/F试验用];使用说明:称取本品21.3g于1L蒸馏水或去离子水中,加热煮沸约1分钟使彻底溶解,分装试管,121℃灭菌15分钟,直立凝固备用;产品规格:250g/瓶;产品用途:用于细菌葡萄糖利用试验,确定发酵型或氧化型
Leeming-Notman培养基;英文名称:Leeming-Notman Medium;产品别名:Leeming-Notman培养基基础;Leeming-Notman培养基;使用说明:称取本品44.0g于1L蒸馏水或去离子水中,加热持续煮沸1分钟,分装三角瓶(建议在瓶底铺撒一层玻璃珠),每80ml加入1支橄榄油1.6ml,121℃高压灭菌15分钟,灭菌结束后请充分摇匀,冷至50℃左右,无菌操作每80ml添加1支40mg,轻轻摇匀,倾注平板,备用;产品规格:500g/瓶;产品用途:用于马拉色菌的培养,每80ml添加1支溶夜(40mg)和1.6ml橄榄油
连四硫酸盐肉汤培养基;英文名称:Fluid Tetrathionate Medium Base;产品别名:连四硫酸盐肉汤培养基基础;连四硫酸盐肉汤培养基;使用说明:称取本品46.0g于1L蒸馏水或去离子水中,加热煮沸,分装,121℃高压灭菌15分钟或115℃高压灭菌30分钟,冷却,冷暗储存备用。临用前,每100ml加入碘溶夜、0.1%煌绿溶夜各一支,混合均匀,边摇匀边分装;产品规格:250g/瓶;产品用途:用于沙门氏菌选择性分离,每100ml添加碘溶夜、0.1%煌绿溶夜各1支
脑-心浸萃夜态培养基;英文名称:Brain-Heart Extraction Liquid Medium;产品别名:脑-心浸萃夜态培养基基础;脑-心浸萃夜态培养基;使用说明:称取本品55.0g于1L蒸馏水或去离子水中,加热溶解,分装,121℃高压灭菌15分钟,备用;产品规格:250g/瓶;产品用途:用于粪链球菌验证,也可用于苛养菌的培养
麦康凯肌醇阿东醇羧苄青霉素琼脂培养基;英文名称:MIAC Agar Base;产品别名:麦康凯肌醇阿东醇羧苄青霉素琼脂培养基基础;MIAC培养基;麦康凯肌醇阿东醇羧苄青霉素琼脂培养基(MIAC);使用说明:称取本品55.1g,加热溶解于1000ml蒸馏水中,分装每瓶200ml,115℃高压灭菌15分钟,冷至50℃左右时,每200ml培养基中加入1支羧苄青霉素溶夜(20mg),混匀,倾入无菌平皿,备用;产品规格:100g/瓶;产品用途:用于克雷伯氏菌选择性分离,每100ml添加1支羧苄青霉素
硫酸亚铁琼脂培养基;英文名称:Ferrous sulfate Agar;产品别名:硫酸亚铁琼脂培养基基础;硫酸亚铁琼脂培养基;使用说明:称取本品48.31g,加热溶解于1000ml蒸馏水中,115℃高压灭菌20分钟,备用;产品规格:250g/瓶;产品用途:用于细菌产试验
LC琼脂培养基;英文名称:Lactobacillus Casei Agar;产品别名:LC琼脂培养基基础;LC琼脂培养基;使用说明:称取本品35.3g于1L蒸馏水或去离子水中,加热煮沸至完全溶解,分装,121℃高压灭菌15分钟,灭菌结束后请摇匀,倾注平板,备用;产品规格:500g/瓶;产品用途:用于干酪乳杆菌的培养和计数
改良CCDA培养基;英文名称:Modified CCDA Medium Base;产品别名:改良CCDA培养基基础;改良CCDA培养基;使用说明:NULL;产品规格:250g/瓶;产品用途:用于弯曲菌选择性分离,每100ml添加1支改良CCDA培养基基础添加剂
抗生素培养基A[PH8.0];英文名称:Medium A(PH8.0);产品别名:抗生素培养基基础A[PH8.0];抗生素培养基A[PH8.0];使用说明:NULL;产品规格:250g/瓶;产品用途:用于抗生素检测
SB肉汤培养基;英文名称:Super Broth;产品别名:SB肉汤培养基基础;SB肉汤培养基;使用说明:NULL;产品规格:250g/瓶;产品用途:用于基因工程大肠杆菌的高密度发酵
脑-心浸萃夜态培养基;英文名称:Brain-Heart Extraction Liquid Medium;产品别名:脑-心浸萃夜态培养基基础;脑-心浸萃夜态培养基;使用说明:称取本品55.0g于1L蒸馏水或去离子水中,加热溶解,分装,121℃高压灭菌15分钟,备用;产品规格:250g/瓶;产品用途:用于粪链球菌验证,也可用于苛养菌的培养
马铃薯葡萄糖琼脂培养基[日本标准用];英文名称:Potato dextrose agar;产品别名:马铃薯葡萄糖琼脂培养基基础[日本标准用];PDA培养基;马铃薯葡萄糖琼脂培养基[日本标准用](PDA);使用说明:称取本品39.0g于1L蒸馏水或去离子水中,加热煮沸持续1分钟以上使溶解,分装,121℃灭菌15分钟,灭菌结束后请摇匀,以防琼脂沉积于器皿底部而凝固,冷至50℃左右,倾注平皿,备用;产品规格:250g/瓶;产品用途:用于霉菌和酵母菌计数
BAT琼脂培养基;英文名称:BAT Agar;产品别名:BAT琼脂培养基基础;BAT琼脂培养基;使用说明:称取本品29.0g,加热溶解于1000ml蒸馏水中,分装,121℃高压灭菌15分钟,冷至45-50℃时,加入适量无菌1 N Hcl或1 NH2SO4调整pH值至4.0±0.2,混匀,倾入无菌平皿,备用;产品规格:250g/瓶;产品用途:用于脂环酸芽孢秆菌检验
TGY琼脂培养基;英文名称:Tryptone Glucose Yeast Agar Medium;产品别名:TGY琼脂培养基基础;TGY琼脂培养基;使用说明:称取本品24.0g于1L蒸馏水或去离子水中,煮沸1分钟使彻底溶解,分装,121℃高压灭菌15分钟或115℃灭菌30分钟,备用。如需添加抗生素,请将培养基灭菌后冷至50℃左右无菌环境下添加;产品规格:250g/瓶;产品用途:用于芽孢菌的培养
培养基;英文名称:Lead Acetate Medium;产品别名:培养基基础;培养基;使用说明:称取本品3.55g于100ml蒸馏水或去离子水中,加热煮沸至完全溶解,121℃高压灭菌15分钟,灭菌结束后请摇匀,以防琼脂沉积于器皿底部而凝固,冷至50-55℃,加入1支无菌10%溶夜,摇匀,制备斜面;产品规格:250g/瓶;产品用途:用于试验,每100ml添加10%溶夜1ml
Luria琼脂培养基;英文名称:Luria Agar Base;产品别名:Luria琼脂培养基基础;Luria琼脂培养基;使用说明:NULL;产品规格:250g/瓶;产品用途:含0.05%NaCl,用于大肠杆菌的培养和保存,视需要每1L培养基中无菌添加10ml20%葡萄糖溶夜
LB琼脂培养基[Lennox];英文名称:LB Agar,Lennox;产品别名:LB琼脂培养基基础[Lennox];LB琼脂培养基[Lennox];使用说明:称取本品35.0g,加热溶解于1000ml蒸馏水中,分装,121℃高压灭菌15min,备用;产品规格:250g/瓶;产品用途:用于分子生物学中大肠杆菌的培养
硫酸亚铁琼脂培养基;英文名称:Ferrous sulfate Agar;产品别名:硫酸亚铁琼脂培养基基础;硫酸亚铁琼脂培养基;使用说明:称取本品48.31g,加热溶解于1000ml蒸馏水中,115℃高压灭菌20分钟,备用;产品规格:250g/瓶;产品用途:用于细菌产试验
半固体琼脂培养基;英文名称:Semisolid Agar;产品别名:半固体琼脂培养基基础;半固体琼脂培养基;使用说明:称取本品22.0g于1L蒸馏水或去离子水中,加热煮沸至完全溶解,分装试管,121℃高压灭菌15分钟,凝固,备用;产品规格:250g/瓶;产品用途:用于细菌动力试验
孟加拉红培养基;英文名称:Rose Bengal Medium;产品别名:孟加拉红培养基基础;虎红培养基;孟加拉红培养基;使用说明:称取本品36.6g于1L蒸馏水或去离子水中,煮沸溶解1分钟,补水至1000ml,分装,121℃灭菌20分钟,灭菌结束后请摇匀以防琼脂沉底于底部而凝固,冷至55℃左右,备用;产品规格:250g/瓶;产品用途:用于真菌的分离和计数
"

![Wort肉汤培养基[源头供货]](https://img.chemicalbook.com/SupplyImg1/2025-01-26/Large/202501261954360025422.jpg)